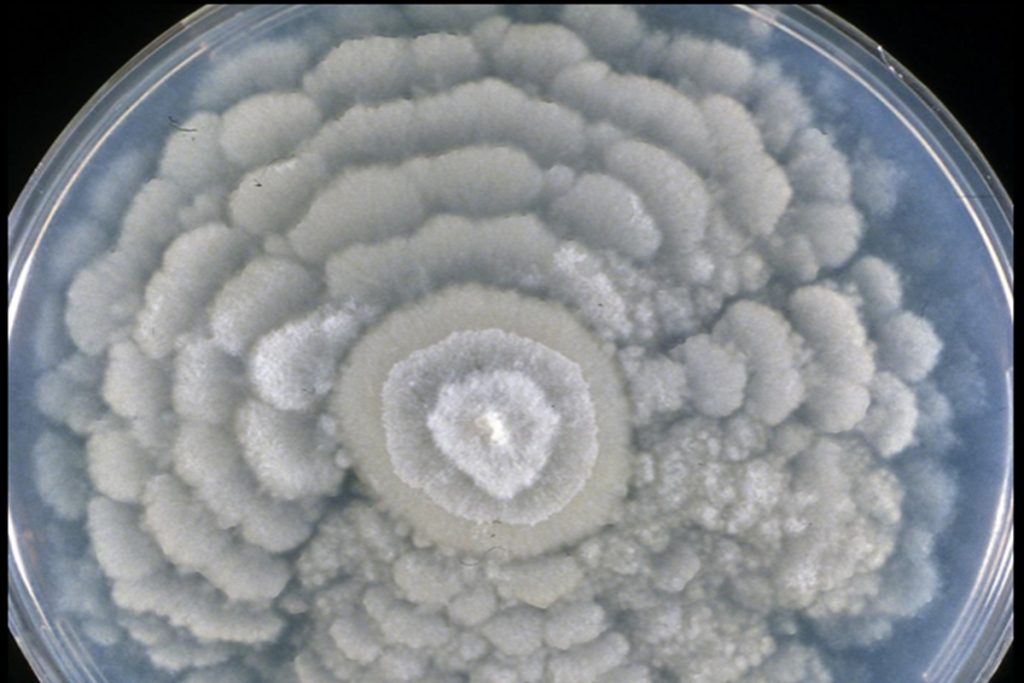

Homem perde vesícula e tem complicações após comprar GLP-1 online

Britânico contou que buscava “solução rápida” para emagrecer e acabou com complicações associadas ao uso do medicamento comprado online
Musk “não entendia muito bem de IA”, diz advogado da OpenAI em contra-ataque

A OpenAI iniciou sua defesa no tribunal federal de Oakland nesta terça-feira (28) com um contra-ataque agressivo à imagem de “salvador da humanidade” de Elon Musk. William Savitt, advogado principal da OpenAI – e veterano que já venceu Musk no caso da aquisição do Twitter –, afirmou ao júri que o bilionário não está agindo […]
Oceanos podem ter abrigado polvos gigantes de quase 20 metros na Pré-História

Um artigo publicado na revista Science na última quinta-feira (23) apresenta evidências de que polvos gigantes podem ter dominado os oceanos há cerca de 100 milhões de anos. Conduzida por cientistas da Universidade de Hokkaido, no Japão, a pesquisa sugere que os primeiros polvos conhecidos não eram apenas animais discretos do fundo do mar, mas […]
Em dez mil anos, a seleção natural segue balizando os humanos; entenda

A seleção natural continua a desempenhar um papel ativo na evolução humana, mesmo após o surgimento da agricultura e das primeiras sociedades sedentárias. Um novo estudo revela que esse processo não apenas persistiu nos últimos dez mil anos, como pode ter se intensificado nesse período, moldando centenas de genes em populações da Eurásia Ocidental. A […]
Amazon lança IA que faz entrevistas de emprego e acelera contratações em massa

A Amazon deu um passo significativo na automação de seus processos de recursos humanos. A gigante de Seattle apresentou nesta terça-feira (28) um novo software projetado para agilizar contratações em larga escala, eliminando uma etapa tradicionalmente essencial: a entrevista presencial conduzida por um recrutador humano. A novidade faz parte de uma estratégia mais ampla da […]
Serra Fluminense: casas para alugar em Penedo pelo Airbnb

Penedo é um daqueles recantos charmosos em meio à porção fluminense da Serra da Mantiqueira. O distrito de Itatiaia carrega, desde 1920, a herança de uma colônia finlandesa que deixou marcas na arquitetura em estilo enxaimel e no jeitinho acolhedor da vila. Essa cultura segue viva em atrações como o shopping a céu aberto Pequena […]
Estudo identifica fungo capaz de influenciar a formação da chuva
Descoberta revela ligação entre micro-organismos, formação de gelo e chuva, com potencial para novas tecnologias
EUA investiga infecções por salmonella ligadas a aves domésticas

Contato com galinhas e outras aves criadas em quintais está associado a casos da doença, alguns com resistência a antibióticos
“Roubar uma instituição de caridade é absolutamente errado”, diz advogado de Musk

O julgamento histórico entre Elon Musk e a OpenAI teve início nesta terça-feira (28), no tribunal federal de Oakland, com uma ofensiva direta da equipe jurídica de Musk contra a liderança da organização. Steven Molo, advogado principal de Musk, abriu os argumentos acusando Sam Altman e Greg Brockman de corromperem a missão de uma organização […]
Por que a gripe tem tantos nomes? Entenda o que é cada um

Com a queda das temperaturas, as dúvidas sobre as doenças respiratórias aumentam. Afinal, você sabe a diferença entre gripe, influenza, H1N1 e H3N2? Embora muita gente utilize esses nomes para explicar a mesma condição, eles identificam variantes específicas do vírus. Em primeiro lugar, precisamos entender que a gripe surge através do vírus influenza. Este agente […]

